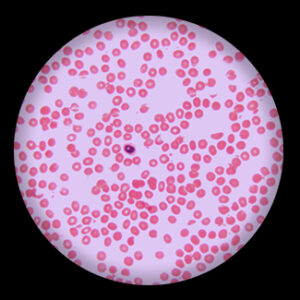
Human Blood Smear

สไลด์ถาวร
คัดกรอง
Showing 51–75 of 286 results
-
Frog Gastrulalate sec.
-
Frog Showing Ovary t.s.
-
Frog Showing Spermary t.s.
-
Home mosquito female mouth parts w.m.
-
Honey Bee Mouth Parts w.m.
-
Honey Bee Third Pair of Legs w.m.
-
Housefly Mouth Parts w.m.
-
Housefly Wing w.m.,Bird Feather
-
Human Blood Smear
-
Human Hair Follicle
-
Human Sweat Glands sec.
-
Hydra Budding The Whole w.m.
-
Hydra c.s.
-
Hydra c.s. through Ovary
-
Hydra c.s. through Spermary
-
Hydra l.s.
-
Hydra w.m.
-
Ileum sec.
-
Insect Antenna w.m.
-
Insect Compound Eye w.m.
-
Kidney Vascular Injection sec.
-
Lactobacillus Acidophilus Grams Positive
-
Large Intestine sec.
-
Laxity Connective Tissue
-
Leech w.m.